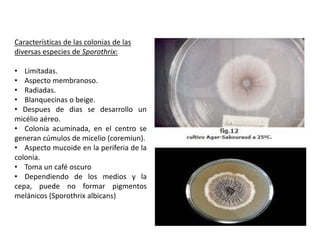
Características de las colonias de las
diversas especies de Sporothrix:

• Limitadas.
• Aspecto membranoso.
• Radiadas.
• Blanquecinas o beige.
• Despues de dias se desarrollo un
micélio aéreo.
• Colonia acuminada, en el centro se
generan cúmulos de micelio (coremiun).
• Aspecto mucoide en la periferia de la
colonia.
• Toma un café oscuro
• Dependiendo de los medios y la
cepa, puede no formar pigmentos
melánicos (Sporothrix albicans)

Este documento describe la esporotricosis, una micosis causada por hongos del género Sporothrix. Explica que afecta principalmente la piel y los ganglios linfáticos, causando lesiones como nódulos y úlceras. También puede afectar los pulmones, huesos y otras partes del cuerpo. Describe los síntomas, factores de riesgo, métodos de diagnóstico e identificación de especies, así como opciones de tratamiento con antifúngicos.